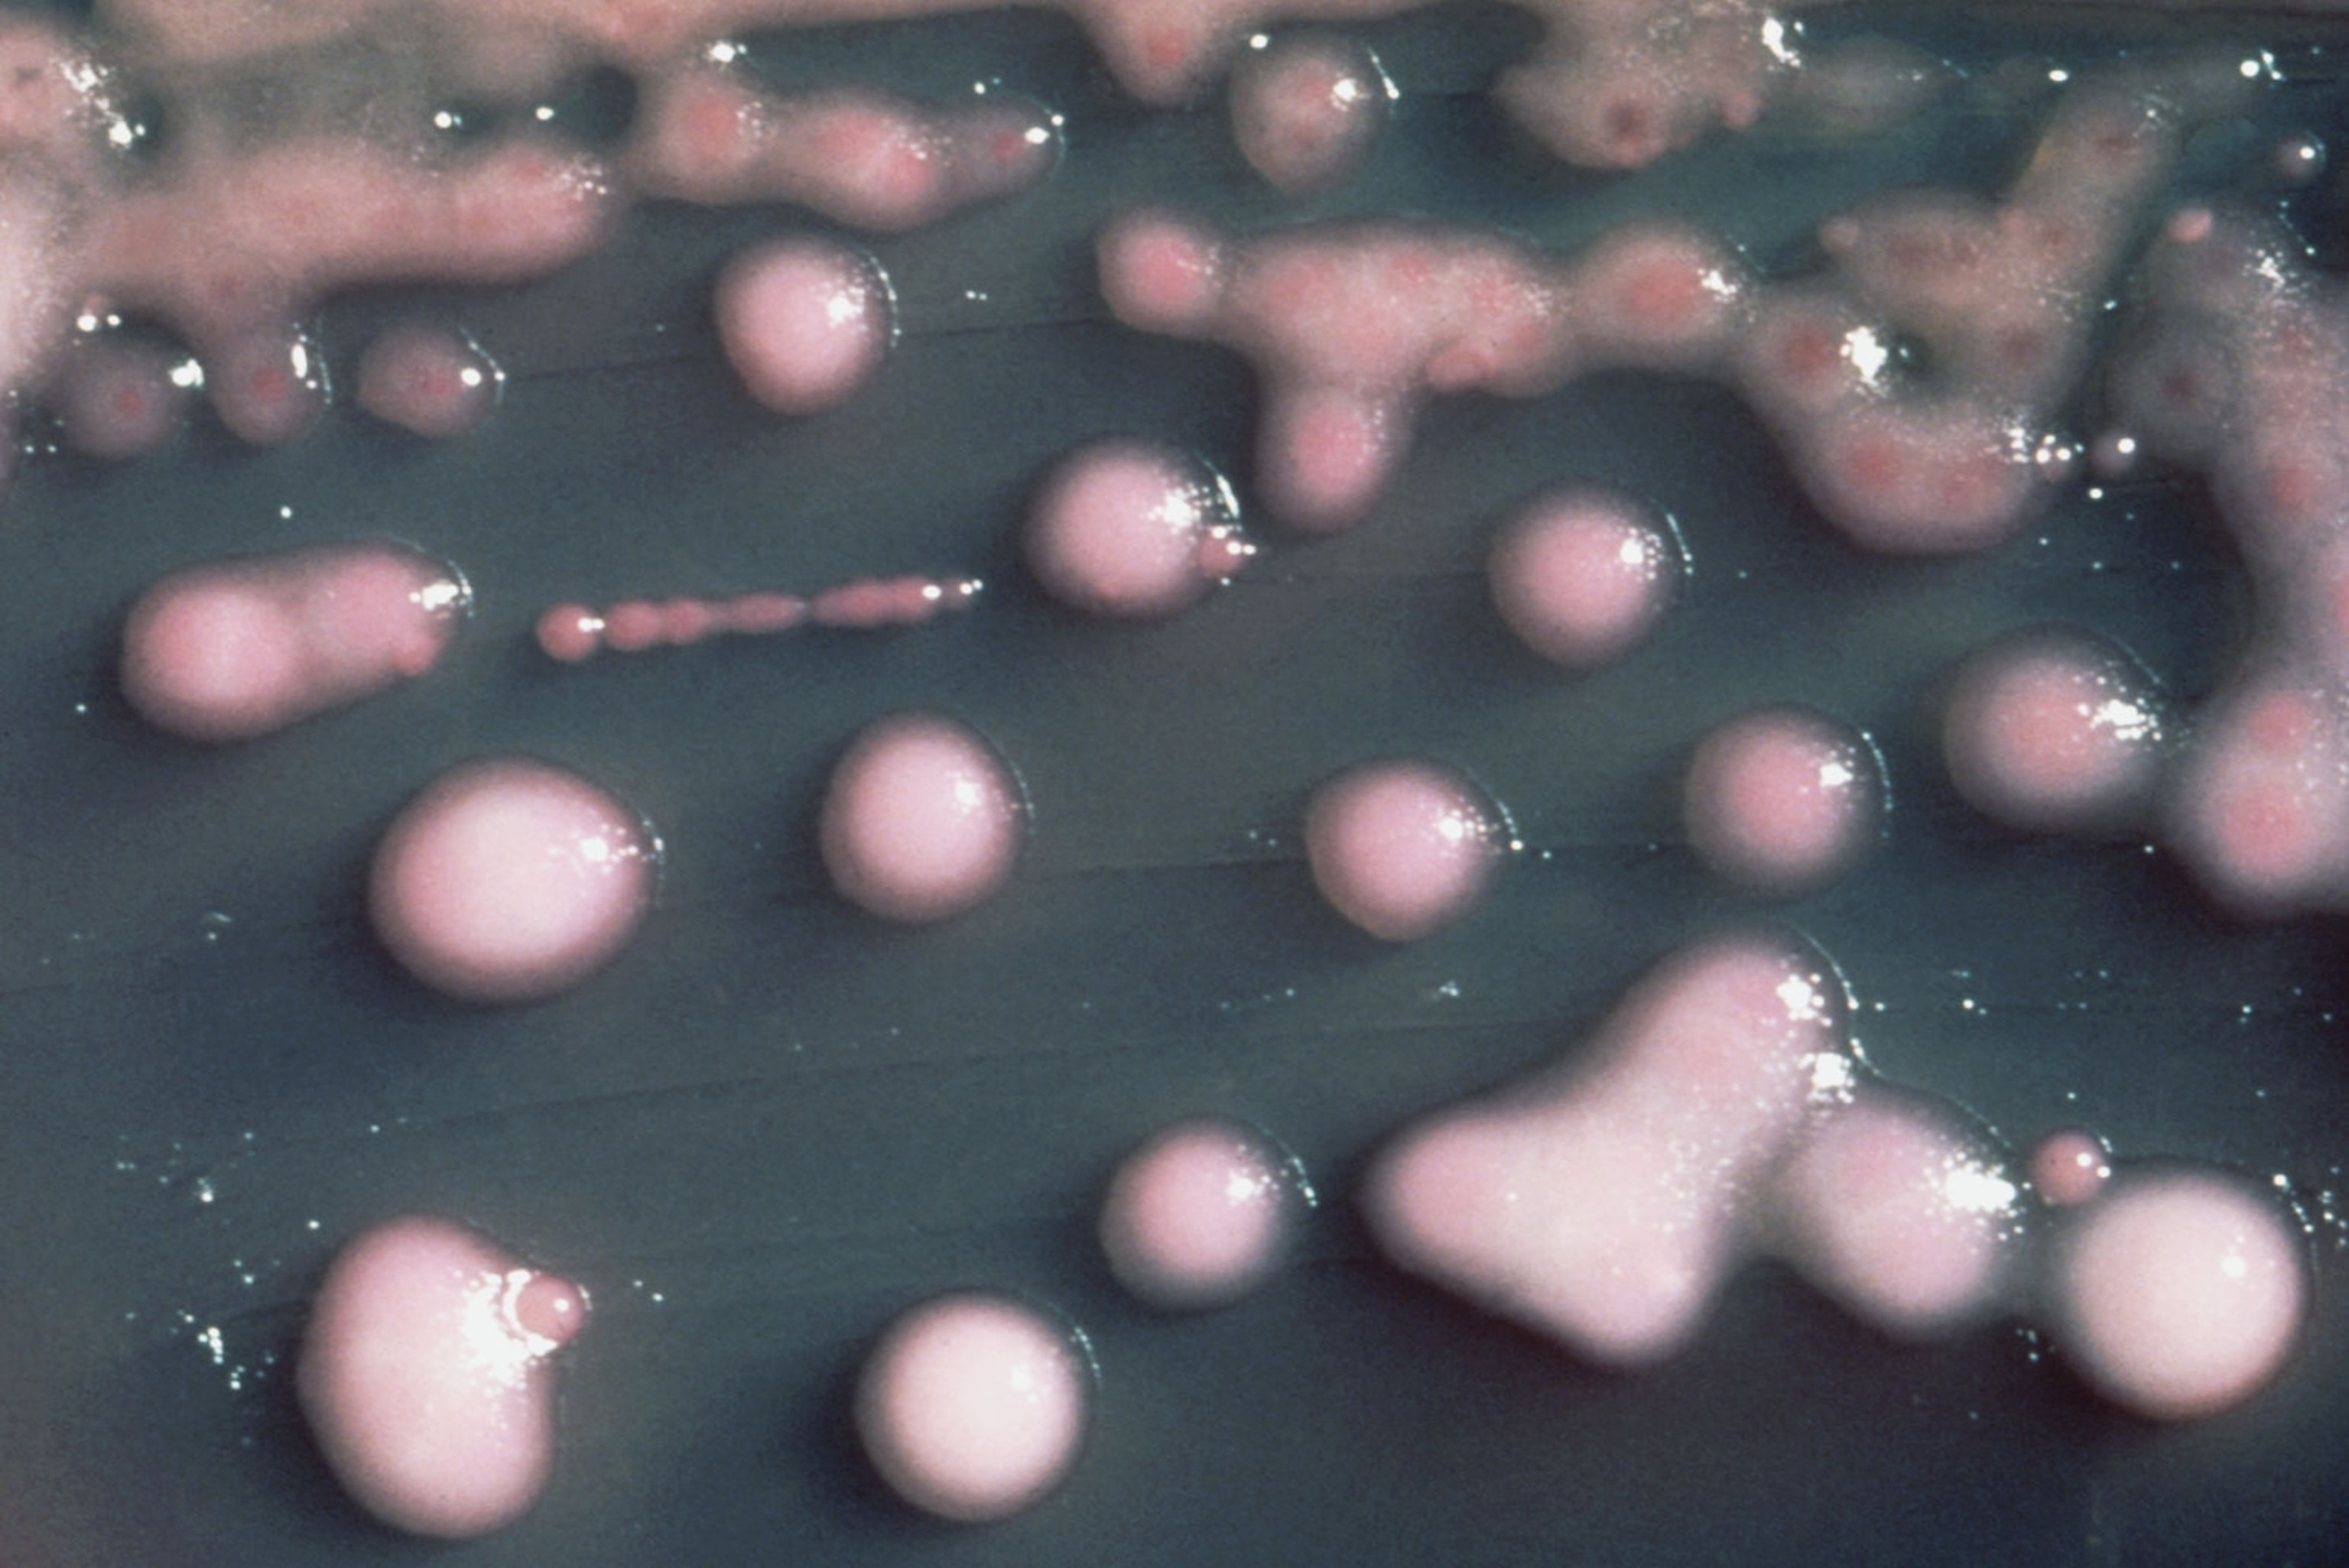

Drug Resistance: Worse, And Still A Lot To Learn
Today starts a week of observances about antibiotic resistance: “Get Smart About Antibiotics” Week by the Centers for Disease Control and Prevention in the US, World Antibiotic Awareness Week, sponsored by the World Health Organization, European Antibiotic Awareness Day on Wednesday, and similar observances in Canada, Australia, New Zealand and Japan—and to mark it, public health authorities are releasing new information about resistant bacteria.
The news is discouraging. The European Centre for Disease Prevention and Control reports that the incidence of highly drug-resistant bacteria is increasing, at the same time that use of the small number of drugs that can cure them is rising. And the WHO says a 12-country survey shows that large numbers of people still don’t understand how antibiotic resistance arises, and are doing things that make it worse.
Eurosurveillance, the ECDC’s peer-reviewed journal, reported on Friday that out of 38 countries, only three have never seen a case of infection with bacteria that can resist the action of carbapenems, a last-resort class of drugs that are used when almost nothing else works. (These bacteria are known as CRE, for carbapenem-resistant, in the US, and CPE, for carbapenemase-producing, in the EU. They take in several categories of highly drug-resistant bugs: KPC, which arose first in the US; OXA, which tends to occur around the Mediterranean; and NDM, the “Indian superbug,” which I wrote a lot about a few years ago.)
Thirteen countries in Europe have seen so many CRE outbreaks that they no longer think of the infection as something periodically imported with travelers or medical tourists, but instead consider it to be something that has spread and become permanently established within their borders. Two years ago, only six countries were in that situation.
In a separate news release this morning, the ECDC translated what those numbers mean: “This means that… most hospitals are seeing patients that cannot be treated” by the last reliable class of powerful antibiotics.

The most recent European data on consumption of antibiotics shows both how the EU got to that level of resistance, and what happens afterward. Use of carbapenems, which doctors go to when multiple other families of antibiotics fail, showed “a significant increasing trend,” the report says. And use of polymyxins such as colistin—an old, toxic antibiotic that is in most cases the sole remaining drug that works once carbapenems are useless—is “increasing significantly” in several countries, though overall use in the EU remains stable.
Meanwhile, the WHO revealed this morning in a lengthy survey of 12 countries (two from each of the regions by which it divides up the globe) that it’s no wonder antibiotic resistance continues to worsen: Everyday consumers possess a lot of misinformation about how it happens and what they might be doing to make it worse.
For instance:
- 64 percent of those surveyed said they would take antibiotics to cure colds and flu.
- 32 percent said they would stop taking antibiotics as soon as they felt better.
- 44 percent think antibiotic resistance is only a problem for people who take antibiotics regularly.
- And 64 percent think that experts will solve the problem of antibiotic resistance before it gets too serious.
Would that were so.